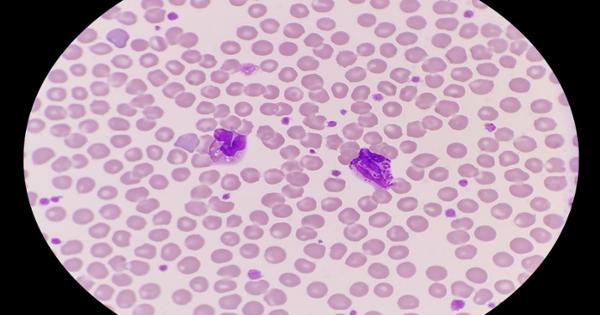
Photo for 
Peripheral Blood Mononuclear Cells (PBMCs)

The CIIDI offers a variety of services and resources to drive the coordinative efforts of academia, government, and industry to foster interdisciplinary collaborations around shared objectives as it relates to Human Diseases.

WHAT CAN CIIDI DO FOR YOUR BASIC, CLINICAL, & TRANSLATIONAL RESEARCH NEEDS?



Sample Tracking & Data Management
-
FreezerPro® Cloud is a clinical sample tracking software solution enabling CIIDI to easily take control of and manage our laboratory's biospecimens.

Through FreezerPro Software systems, we can accurately and efficiently store and locate samples, generate and distribute sampling reports across all or individual boxes, racks, shelves, or any other storage container, and efficiently produce aliquots and, if necessary, trace those samples back to the originating source(s). This last measure provides the center with accurate accounting for the “on-hand” sample vials and the ability to identify the source vials in the event a situation dictates that need.
-
REDCap is a secure web application for building and managing online surveys and databases.

While REDCap can be used to collect virtually any type of data in any environment (including compliance with 21 CFR Part 11, FISMA, HIPAA, and GDPR), it is specifically geared to support online and offline data capture for research studies and operations.
Cold Storage
-
Minus 80 Degrees Celsius Freezer

The Thermo Scientific TSX60086A ultra-low temperature freezer has a capacity of 28.8 cubic feet (holds 600 2" cryoboxes) with a temperature range of -50° to -86°C
-
MVE CryoSystem 4000

MVE Cryo-System Series combines the benefits of low nitrogen consumption with mid-range vial capacity to meet the diverse needs of today's professionals worldwide
-
The BioStore III Cryo

The BioStore III Cryo provides the best in class automated storage solution for cellular products and other materials requiring storage temperatures below glass transition (Tg)
High Quality Human Samples
-
Peripheral Blood Mononuclear Cells (PBMCs)
Human Peripheral Blood Mononuclear Cells (PBMC) from whole blood are obtained from different diagnostic donors and isolated within 24 hours
-
Plasma

Fresh or frozen human plasma samples derived from whole blood of diseased donors, obtained using standard blood fraction separation procedures
-
Serum

A wide range of human serum samples from common infectious, inflammatory, and/or immunological diseases
*To learn more about CIIDI resources, contact:

James Adkins
Clinical Research Director Internal Medicine
- ADKINSJL1@ETSU.EDU
- 423-439-6408
- PO Box 70422Johnson City, TN

Joy Bohannon
Executive Director Internal Medicine
- MICHAELJ@ETSU.EDU
- 423-439-6424
- PO Box 70422 Johnson City, TN
 Possible Outlook Issues
Possible Outlook Issues  Stout Drive Road Closure
Stout Drive Road Closure